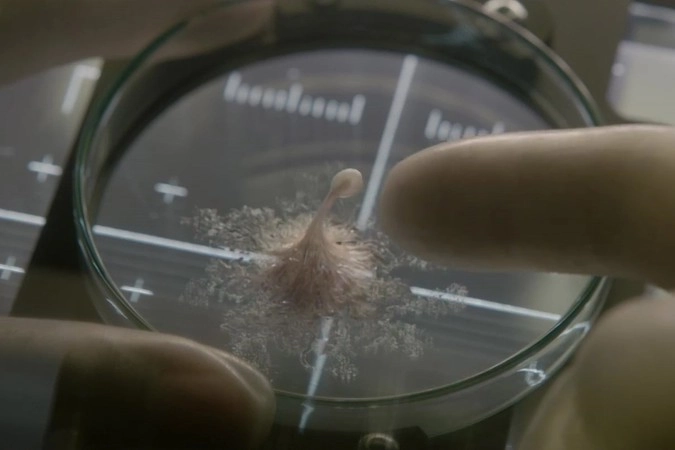

Кино: «Живое» — безупречный космический ужастик
- 23 марта 2017 07:32
- Максим Марков
«Живое» (Life)
США, реж. Даниэль Эспиноса, в ролях: Джейк Джилленхол, Ребекка Фергюсон, Райан Рейнольдс, Ольга Дыховичная, Хироюки Санада, Эрион Бакаре.
Международная космическая станция получает капсулу с образцами грунта Марса — и с первым неопровержимым доказательством внеземной жизни: крупным одноклеточным с волосками-жгутиками, похожими на ресницы. Ликование охватывает всю Землю, «марсианина» называют Келвином, и на этом радостном фоне как-то забывается, что «это неконтролируемый опасный эксперимент», где первая ошибка окажется и последней…
Трейлер фильма «Живое»
Если коротко, то «Живое» Даниэля Эспиносы — новая классика. Тот безукоризненный ужастик, что воскрешает в памяти образы из «Чужого» и «Нечто», а по техническому совершенству максимально близко приближается к «Гравитации».
Он идеален по содержанию: всё на месте, всё работает, никакого лишнего мусора — совсем как на настоящей орбитальной станции.
Он безупречен по форме: обратите внимание хотя бы на составляющий весь пролог долгий план в невесомости — изумительно сделано!
Здесь отличный главный спецэффект (такого инопланетянина — в виде морской звезды или медузы — вы, вероятно, раньше не видели) и крепкие актёрские работы.
Это фильм, который будет казаться вам «знакомым» и «понятным», но при этом напугает вас до дрожи — наверняка, обязательно, всенепременно.
Очень здорово. Очень круто. С рядом воистину великих решений. Браво.
Всё прочее будет уже пустословием, но всё же добавим пару моментов.
Во-первых, от внимательного глаза уже не укрылось, что одну из ролей в этой картине играет наша Ольга Дыховичная («Велкам хом» не прошёл даром). Конечно, образ русского участника международной космической команды — не самое оригинальное, что можно было бы придумать (Александр Балуев, вспомним, тоже через такое проходил), но тем не менее: наша актриса в одном кадре с Джилленхолом и Рейнольдсом — это очень круто.
К тому же Дыховичная здесь не абы кто, а командир экипажа (Екатерина Головкина), во время экскурсии по МКС сообщающая, что «всё это благодаря России, а также Китаю и США». Учитывая, что озвученная стоимость станции — два миллиарда долларов, то получается, что тут мы как бы отыгрались за сбитый во всё той же «Гравитации» спутник (а сам Эспиноса, будем считать, «прощён» теперь за «Номер 44»).
Ролик фильма «Живое»
Во-вторых касается героя Джилленхола, орбитального долгожителя, намеренно (кажется) путающего зрителям все временные ориентиры. Вот вроде бы и говорится, что на Земле уже проживает восемь миллиардов человек, а сама станция болтается в космосе три десятилетия, а он — то вспоминает Ирак, то день, когда взорвался «Челленджер».
Конечно, совершенно неважно, когда именно разворачиваются события фильма, сейчас или же в каком-то отдалённом будущем, но, любуясь идеальной конструкцией всего остального, волей-неволей обращаешь внимание на подобные мелочи.
К тому же, как не заметить признание Дэвида, что он видел «Реаниматора»: что же он тогда «Чужого»-то забыл посмотреть?!.
Но это детали; вернёмся под конец к похвалам. «Живое» — то кино, которое, простите за тавтологию, попросту обречено на долгую жизнь. Прикоснитесь к прекрасному уже сегодня.
- Телеграм
- Дзен
- Подписывайтесь на наши каналы и первыми узнавайте о главных новостях и важнейших событиях дня.

Войти через социальные сети: